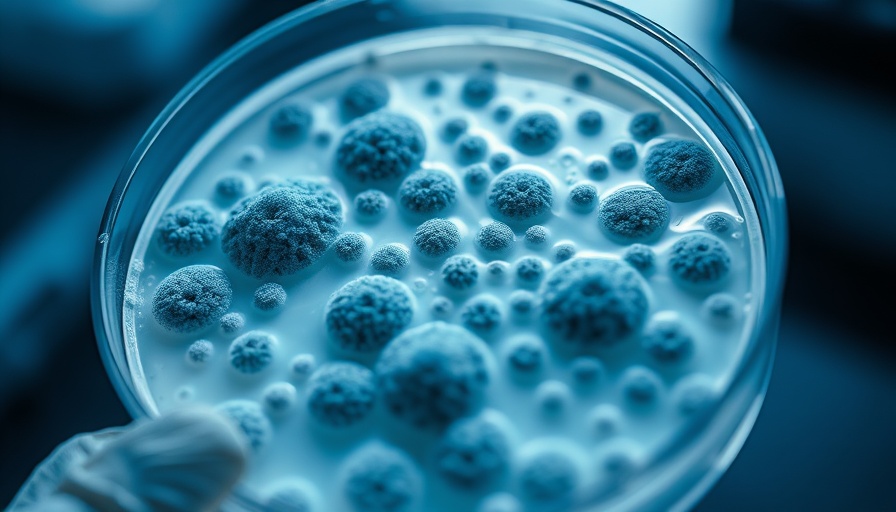

Unlocking a New Frontier in Fungal Education
In a world where the knowledge of health-related subjects can mean the difference between wellness and serious medical complications, access to reliable educational tools is essential. Enter the Dr Fungus app, launched recently by Dr. Matthew Pullen from the University of Minnesota, which serves as a platform dedicated to informing users about fungal infections and antifungal treatments. With features tailored to clinicians and researchers, this app promises to make critical health information easily accessible to all.
A User-Friendly Resource for Everyone
The Dr Fungus app, now available on both Apple and Android platforms, empowers users to explore an array of topics concerning fungi—from the infections they cause to the medications that combat them. Parents looking to understand health issues that may affect their children can benefit from this wealth of information, often made daunting by medical terminology and complexity. For parents, it’s essential to have straightforward access to this knowledge, particularly when confronted with health decisions for their families.
The Importance of Early Fungal Education
Fungal infections are surprisingly common and can impact anyone, including children. Ringworm, tinea, and other fungal-related diseases are notoriously easy to catch yet often overlooked. A greater understanding of these infections can help parents safeguard their children from common communicable diseases. The app aims to provide detailed descriptions, case studies, and preventative advice that can be taken home to contribute to family health.
Expert Insights Accessible at Your Fingertips
The app offers various resources, including monthly case studies that encourage critical thinking among users. Paired with photographs and questions, these case studies can serve as excellent conversation starters for parents discussing health matters with their children, unveiling a world of biology that’s both fascinating and useful. As Dr. Pullen highlights, even if you're not in the medical field, the knowledge within the app is valuable and applicable to everyday familial situations.
Understanding the Effects of Fungi
Fungi play a dual role in our ecosystem—they can be beneficial, as is the case with certain mushrooms and yeast, but they can also be harmful when pathogenic. Parents would benefit from understanding these nuances when discussing health education with their kids. The app covers these concepts, making it a handy device-free educational tool to mitigate screen time while fostering learning.
What’s Next for Dr Fungus?
Looking ahead, Dr. Pullen aims to expand the Dr Fungus app with information regarding active clinical trials. This information could empower parents and caregivers to make informed choices about potential treatment paths, especially if they are faced with novel fungal infections. As these developments unfold, the app will become an even more valuable resource for managing health and wellness.
Enhancing Family Conversations About Health
Given the rise in fungal infections and their impact on everyday life, the Dr Fungus app is not just a digital resource, but a means for initiating important health dialogues within families. By utilizing this app, parents can teach their children about hygiene, health, and the importance of asking the right questions when it comes to their overall well-being.
Take Action for Your Family's Health Today!
If you’re a parent looking to better understand fungal infections and treatments, consider downloading the Dr Fungus app. Equip your family with knowledge and proactive health practices. Knowledge is power, especially when it comes to ensuring the safety and health of your children.
 Add Row
Add Row  Add
Add 




Write A Comment